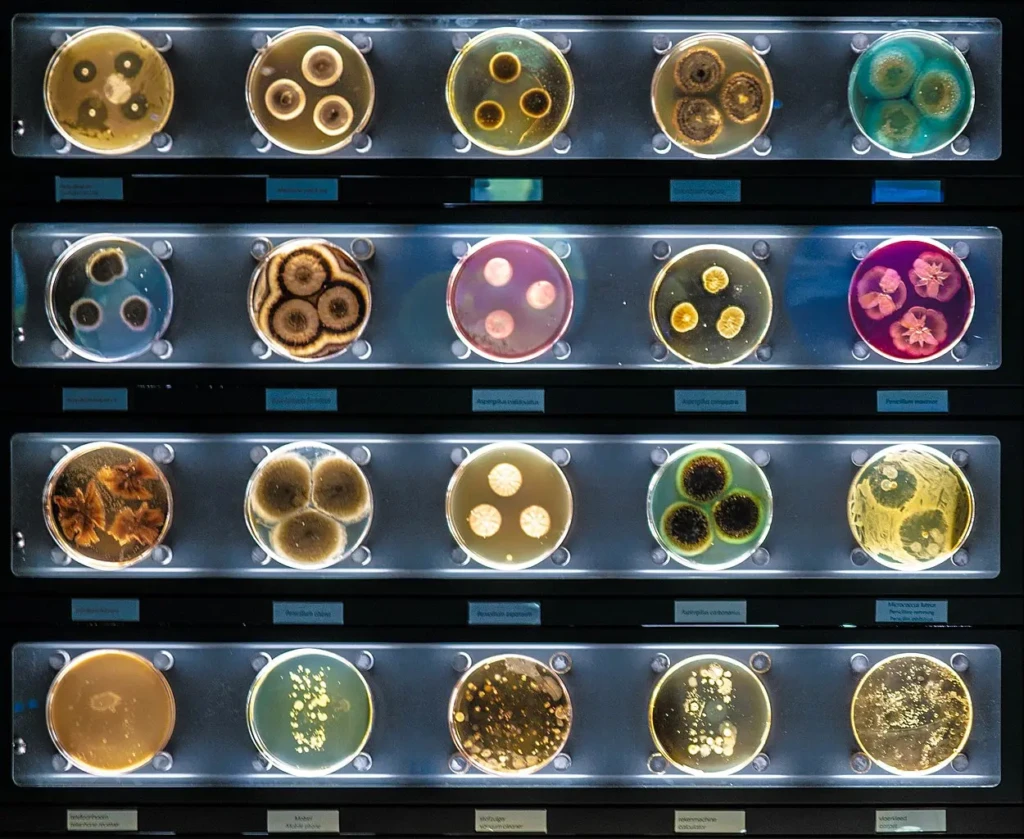
Micropia_Museum_Amsterdam_5

XTREMOLIFE’s ambition
is to bioprospect extremophilic micro-organisms from desert, polar, and volcanic hotspots and accelerate the biodiscovery of new bioactive compounds.
Introducing Xtremolife
Our plan is to go to the toughest places on earth to find the toughest microbes. We aim to understand what makes them thrive in places where most life forms would die. This can help us understand how life works (even outside of the planet) and to create novel drugs, enzymes and bioactive compounds.
Xtremolife will deliver a data base of EU extremophilic culture collection – EXTREMO-BANK-, select newly isolated strains, study their metabolism, scale up their production, produce an exploitation roadmap and businesses cases, and execute an unusual communication plan.
Our Sampling Locations:
Exploring Extreme Hotspots
The Antarctic
Conditions: Polar, cold, variable salinity
The Canary Islands - Spain
Conditions: Volcanic, high temperature, low pH
The Tabernas Desert - Spain
Conditions: Desertic, hypersaline, high temperature, low rainfall
Our methodology:
From environmental sampling to bioactive compound validation
Bioprospecting
The exploration of extremophilic micro-organisms to uncover their phenotypes and genotypes
Biodiscovery
The combination of genomics, metabolomics, and bioactivity assessments to identify bioactive molecules with beneficial effects

Key Figures
Months
0
Partners
0
Countries
0
Budget
0
M €
Subscribe to the Synergy at the Extreme Cluster Newsletter
A cluster of 4 EU Projects exploring extreme environments